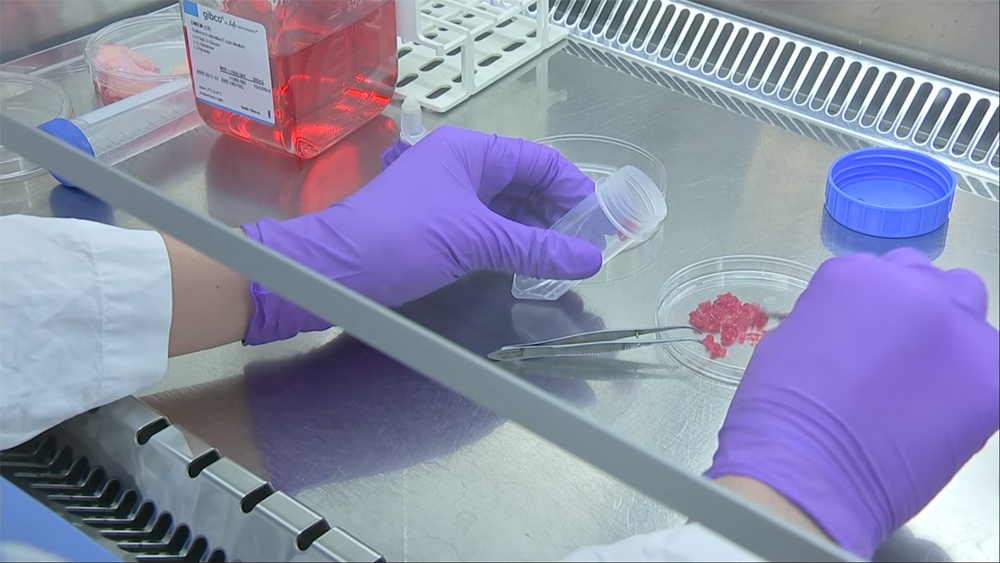
Пища недалекого будущего. Как готовят мясо из пробирки и почему мы все скоро будем его есть - 5 Пища недалекого будущего. Как готовят мясо из пробирки и почему мы все скоро будем его есть - 5

Выращенное в лабораториях мясо начнут подавать в ресторанах Калифорнии уже в этом году. К 2020-му оно станет дешевле обычного, и на него начнут переключаться крупные сети фастфуда, а дальше дело дойдет до супермаркетов. Об этом заявила компания JUST, один из передовых разработчиков «мяса из пробирки». На это же рассчитывают Билл Гейтс, Сергей Брин, Ричард Брэнсон и многие другие инвесторы в технологию.

Аппетитно?
В 2008-м производство в лаборатории куска говядины весом 250 грамм обходилось в $1 млн. В 2013-м бургер, выращенный в Лондоне ради эксперимента, стоил $325 тысяч. Сейчас его цена упала до $11. В ближайшие несколько лет искусственное мясо гарантированно станет дешевле натурального. Зачем нам это надо, как ученые выращивают «Мясо 2.0», какой у него вкус и почему эта технология изменит наш мир.
Что не так с нынешним мясом?
Свинина, говядина, курятина. Вкусные и естественные продукты, к которым мы привыкли. Но, к сожалению, долго так продолжаться не может.
Первая, главная причина – глобальное потепление. Одна корова за год «выпускает» от 70 до 120 кг метана. Метан – один из парниковых газов, как и углекислый газ (CO2). Но его негативное влияние на климат в 23 раза сильнее. То есть, 100 кг метана от коровы – эквивалент 2300 кг диоксида углерода. Это примерно 1000 литров бензина. С машиной, потребляющей 8 литров на 100 км, можно каждый год проезжать 12 500 км, и только тогда вы сравняетесь во влиянии на климат с одной коровой, спокойно жевавшей травку на ферме. Ко всему прочему, коров и быков в мире намного больше, чем автомобилей. По последним оценкам, 1,5 млрд против 1,2 млрд.

Конечно, суммарно транспорт в мире способствует глобальному потеплению больше, чем мирные телушки. Один контейнеровоз или круизный лайнер «парит» как 80-150 тысяч машин. Но влияние скота нельзя недооценивать. На каждый 1 кг говядины в магазине – в атмосферу выбрасывается эквивалент 35 кг углекислого газа. Килограмм свинины – 6,35 кг CO2, килограмм курятины – 4,57 кг CO2. Сейчас оценивают, что 18% выбросов, влияющих на глобальное потепление, идут именно от домашних животных. Сколько бы заводов ни переходило на солнечную энергетику, сколько бы электромобилей ни выпускал Илон Маск, этот фактор с нами остается.
Проблема еще и в том, что человечество продолжает расти. По оценкам ученых, к 2050-му году нас будет 9,6 млрд. Урбанизация и рост среднего класса приведут к дополнительному повышению спроса на мясо. По данным Продовольственной и сельскохозяйственной организации ООН, миру придется вырабатывать на 70% больше еды. И говорят, что с текущими технологиями это попросту невозможно.

Сколько мяса (и яиц) потреблялось в 2005-м, и сколько будет потребляться в 2050-м
Одним из тех, кто придерживается такого мнения, является Билл Гейтс. По его словам, если нас будет больше 9 млрд, накормить всех людей натуральным мясом попросту не получится. За последние несколько лет он инвестировал в дюжину стартапов, выращивающих мясо в лабораториях. Его примеру последовали Ричард Брэнсон и миллиардеры из Гонконга, Китая и Индии. В своем личном блоге в заметке о будущем продуктов питания в 2013-м Гейтс написал:
Выращивание животных на мясо требует много земли и воды, и серьезно вредит нашей планете. Если сказать прямо, у нас нет возможности прокормить больше девяти миллиардов людей. И в то же время мы не можем попросить каждого стать вегетарианцем. Поэтому мы должны найти варианты производства мяса без истощения наших ресурсов.
Вторая причина (её частично коснулся Билл Гейтс) – фермы и пастбища для животных занимают очень много места на планете. Очень много. Под содержание скота сейчас отведено 30% всей сухой поверхности Земли. Часто это пастбища на месте бывших лесов. Около 70% бывших лесов Амазонки теперь вырублены под выпас животных. А на 33% всех пахотных земель выращивается корм для скота. Места для людей и природы остается всё меньше.
Третья причина – это еще и невыгодно. Производство мяса – дико неэффективный процесс. Чтобы сделать 1 кг говядины, надо потратить больше 38 кг корма и почти 4 тысячи литров воды (учитывая поливы кукурузы и сои). На коров уходит в 20 раз больше пищи, чем требуется для устранения проблемы голода на планете. А если нас станет 9,6 млрд, для производства мяса не хватит воды (есть, конечно, вариант с опреснением, но это дополнительные затраты и другие проблемы).

Выращенное в лаборатории мясо уже сейчас требует в 100 раз меньше земли и в 5,5 раз меньше воды, чем натуральное мясо, при том, что технология еще не отшлифована. По последним оценкам ученых из Оксфорда, если мы сможем на него перейти, это на 78-96% уменьшит «выхлопы» парниковых газов от скота, снизит потребление энергии на 7-45% и сохранит 82%-96% пресной воды (такие сильные разбросы связаны с разными типами мяса).
Четвертая причина перейти на «мясо из пробирки» – понятно, уменьшение числа убийств и страданий животных. Кому-то этот фактор кажется бессмысленным, а для кого-то он является важнейшим. Организация по защите прав животных (PETA) вкладывает свои деньги в технологию выращивания наггетсов и бифштексов. В 2014-м она предложила $1 млн награды первому ученому, который выпустит на рынок выращенное в лаборатории куриное мясо:
Мы верим, что это первый важный шаг в создании экологически чистого, гуманно произведенного настоящего мяса в руки и рты тех людей, которые настаивают на поедании плоти животных.
Как делают мясо в пробирке
На самом деле, конечно, «чистое» или «культурное» мясо (как его сейчас пытаются брендировать на Западе) выращивают не в пробирке, а в чашке Петри или специальном контейнере. Есть десятки компаний со своими подходами, но в целом процесс делится на три этапа:
1. Сначала собирают клетки, склонные к быстрому размножению. Это могут быть эмбриональные стволовые клетки, взрослые стволовые клетки, миосателлитные клетки или миобласты. На этом этапе ученым нужно животное (или идеально сохраненные клетки, но до этого еще не дошли).
2. Клетки обрабатывают, добавляя протеины, способствующие росту тканей. Потом их помещают в культуральную среду, в биореактор. Он выполняет роль кровеносных сосудов, снабжая клетки всем необходимым, и давая им условия для роста. Главный питательный элемент клеток – плазма крови животного (чаще всего – эмбриона). В неё добавляют смесь сахаров, аминокислот, витаминов и минералов. Чтобы мышечная ткань правильно развивалась, её выращивают под давлением, симулируя натуральные условия. Также в биореактор подаются тепло и кислород. По существу, клетки даже не подозревают, что они растут вне животного.

3. Чтобы сделать мясо трехмерным, а не плоским, лаборатории используют своеобразные «строительные леса». В идеале они тоже должны быть съедобными, и периодически двигаться, растягивая развивающуюся мышечную ткань, имитируя движения реального тела. Пока что на этом этапе не концентрируются, но все согласны, что без него создание сколько-нибудь правдоподобного мяса невозможно. Ни консистенция, ни текстура у массы, спокойно развивавшейся в чашке Петри, современного едока не обманут.

Полностью освободить животных от работы, как видим, пока не получается. И на первом, и на втором этапе пока что нужны элементы от реального тела. Но теоретически скоро можно будет обойтись без него. Стволовые клетки – клонировать или выращивать отдельно, а плазме крови – найти заменитель. Ученые говорят, что в идеальных условиях за два месяца выращивания «культурного» мяса можно из 10 клеток свиньи получить 50 000 тонн продукта.
А вот те, кто называют это мясо «чистым» – слегка лукавят. Для его выращивания нужны консерванты, вроде бензоата натрия, чтобы защитить мясо от грибка. Также на разных стадиях используется коллагеновый порошок, ксантан, маннит и так далее. Если вы беспокоитесь, что «животных на фермах пичкают антибиотиками и всякой химией», с пришествием мяса из лабораторий ваши страхи усилятся.

Впрочем, по словам компаний-разработчиков, у «культурного мяса» есть одно преимущество перед натуральным продуктом. Оно может оказаться полезным для талии. С некоторыми мясными продуктами, вроде бифштексов, важной частью текстуры и вкуса является жир. Фирмы, «выращивающие» мышечные клетки, могут контролировать, какой тип жира будет расти вместе с их мясом. Они могут давать развиваться только полезным жирам, вроде ненасыщенных жирных кислот омега-3, улучшающих работу сердца и ускоряющих обмен веществ.
Первая цель – фуа-гра
Есть одна еда, со стоимостью которой легко соревноваться. Печень перекормленного гуся или утки, один из самых дорогих видов мяса. По $50 за фунт, больше $110 за кг! С такой ценой «пробирочный» продукт уже сейчас кажется выгодной альтернативой. Выращивать гусиную или утиную печень в лаборатории ничуть не сложнее, чем куриные наггетсы, а прибыль гораздо больше.

Эксперименты с фуа-гра сейчас проводит компания JUST (бывшая Hampton Creek). Цель – начать её поставки в американские рестораны уже в этом году. У компании есть опыт запуска успешных продуктов на рынок. В ее портфолио – майонез без яиц и шоколадные чипсы, популярные у веганов.
Борцы за права животных давно выступают против методов, которыми делается фуа-гра. Гусям и уткам на фермах насильно запихивают трубку с пищей в горло и кормят до тех пор, пока те не могут ходить. У них нарушается процесс обмена веществ, а печень, пытаясь всё это обработать, раздувается в 10 раз больше своих нормальных размеров.

Кормежка на ферме, делающей фуа-гра
В сети полно видео от активистов, прорвавшихся на американские фермы и тайно снявших состояние находящихся там животных. Особого шума наделали кадры крысы, съедающей живого гуся сзади, потому что он не способен себя защитить (детали расписывать не хочется, желающие углубиться в тему могут до сих пор найти видео на ютубе). После разгоревшегося скандала Калифорния запретила производство и продажу фуа-гра на своей территории. Для тамошних любителей деликатеса лабораторная фуа-гра станет шансом легально купить продукт, не пересекая границы штата. А сторонники гуманного обращения с животными смогут спать спокойно. Команде JUST нужен только один гусь-донор, и крыс к нему точно не подпускают.
Есть только одна, ма-аленькая проблемка. Гурманов, согласных отдать любые деньги за свою фуа-гра, почти невозможно переубедить. Они тонко различают вкус (или, по крайней мере, так думают), и не хотят компромиссов. Им проще пойти на черный рынок или потратить полдня, съездив за своей любимой печенью. А то, что лабораторное мясо экономит им пару сотен долларов, вообще не фактор. JUST, MosaMeat и другие лаборатории говорят, что на этих клиентов они, по правде, почти не рассчитывают. Им важнее, чтобы каждый новый покупатель, решивший попробовать фуа-гра, сначала шел покупать их продукт.

Фуа-гра из лаборатории
О вкусе
Главная сложность в том, что продукт из лабораторий должен быть точь-в-точь как то мясо, к которому мы привыкли. Об этом говорит СЕО компании MosaMeat Питер Верстейт:
Когда они пробуют продукт, у них должно быть впечатление, что это мясо. Не «это выглядит как мято» или «это похоже на мясо», это просто должно быть мясо. В этом главная сложность.
Грубо говоря, тут работает эффект "зловещей долины". Знаете, когда в фильмах или играх проще принять что-то совершенно новое, или что-то очевидно фальшивое, чем прекрасную компьютерную графику человека, выполненную на 99%? Мы прекрасно научились отличать этот 1%, потому что мы сталкиваемся с лицами людей ежедневно. Попытка точно отразить реального человека может достичь обратного эффекта – нам будет казаться, что это какой-то страшный робот или инопланетянин, надевший человеческую кожу.

С искусственным мясом – та же история. Грубо говоря, если вкус вам полностью незнакомый, говорит «О, это что-то новое». А если вкус похож на 99%, но есть какое-то отличие, у

Лабораторное мясо
За последний 1% «похожести» сейчас и борются разработчики мяса из биореактора. Главная проблема – текстура. Мясо, которое росло на кости, имеет мышцы и жир в конкретной консистенции, которую очень тяжело повторить. Поэтому до выращенного стейка еще несколько лет. А вот бургеры и наггетсы делают уже сейчас, и к их вкусу особых претензий нет

До этого еще далеко
В мае 2013 года в Лондоне сделали первый бургер из «культурного мяса». Он состоял из 20 000 тонких полосочек мышечной ткани и стоил $325 тысячи, которые поступили от анонимного мецената (потом оказалось, что это был Сергей Брин). Попробовав бургер, кулинарный эксперт Ханни Руцлер дала свою оценку:
У него очень сильный вкус, даже на месте прожарки. Я знаю, что здесь нет жира, и он не такой сочный, как мне хотелось бы, но вкус очень интенсивный, он бьет по рецепторам. Если бы мы вслепую оценивали вкус, я бы сказала, что этот продукт ближе к мясу, чем к соевой копии.
Разработки 2018 года по вкусу еще больше похожи на натуральное мясо. И цена у них намного адекватнее – от $11,36 за кг (некоторые фирмы пока выставляют ценники $1000-$2400, но их цены тоже быстро идут вниз). Пол Шапиро, автор бестселлера «Чистое мясо: как выращивание мяса без животных произведет революцию в обеде и в мире», попробовал последние лабораторные версии говядины, курятины, рыбы, утки, фуа-гра и чоризо (испанских свиных сосисок). По его словам,
По вкусу они точно как мясо, потому что это и есть мясо.
Но не у всех пока такие прогрессивные взгляды. В исследовании 2014 года 80% американцев сказали, что не готовы есть мясо, выращенное в лаборатории. В 2017-м только 30% заявили, что открыты к тому, чтобы включить такое мясо в свою диету, и иногда употреблять его взамен традиционному. Среди тех, кто против всех этих «экспериментов сумасшедших ученых», за продуктом даже закрепилась кличка. Его уничижительно называют «франкен-мясом».

Похоже на настоящее?
Сторонники «культурного мяса» и компании, которые его разрабатывают, считают, что время на их стороне. Пол Шапиро говорит:
Посмотрите на примеры истории. Раньше лед добывали на озере, и массивными кусками везли на продажу. Теперь мы получаем лед в комфорте нашей кухни. Мы называем это «морозилка», и не видим в этом ничего искусственного. Мороженое, йогурты, пиво, всё это изменилось благодаря технологиям. Надо принять, что так же будет и с мясом. Другого пути у нас нет.

P.S. Pochtoy.com доставляет покупки из магазинов США. От $8,99 за полкило. А если зарегистрироваться у нас с кодом Geektimes, вам на счет зачисляется $7.
Автор: Pochtoycom






